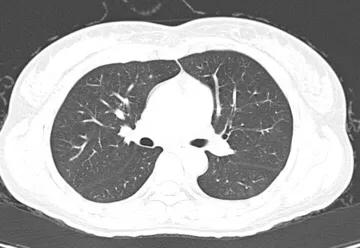
讲解医学影像的书,医学影像学几年

细说医学影像学
人类在世,少不了有点什么不舒服或者疾病,要和各式各样的医院、不同的医师打交道。到了医院,挂了号,看了专科医师,医师们会开出各式各样的实验室检验申请单(化验单)、影像检查申请单,等等。如果不是对医院各类功能分区有研究的朋友,一般来说只能按照医师的医嘱去执行各类检查。当然,相信医师,是患者的基本要求。那么面对众多的影像检查方法,出于了解的目的,我们不妨来认识一下影像诊断学。同时,也对各类检查的适应症和禁忌症做一些阐述,毕竟,一些医学检查有射线(辐射),大家可能会产生一些误解。
医学影像学,广义上来讲,凡是利用影像、图像来对疾病作出诊断的方法和手段都可以称作医学影像学的范畴,比如说主要包括X光机、CT(X线计算机断层扫描仪)、MRI(磁共振成像)、DSA(数字减影血管造影术)、正电子发射断层扫描仪(PET)、超声(分B超、彩色多普勒超声、心脏彩超、三维彩超)、心电图仪器、脑电图仪器等。
狭义上来说,医学影像学包含了传统X线、CT、MRI、超声,这也是我们常说的医学影像学,同时,也是最接地气的,符合了我国的国情。但是,在国内,超声诊断学相对独立,自成一个学科或科室,在国外归纳在一个科室的。这些诊断技术各有特点,各有优缺点,互为补充。医学影像学是最近30年,随着CT和MRI的发展而命名的,英文是Medical Diagnostic Imaging,它源于较早的一个名词 —— 放射诊断学。
DSA(数字减影血管造影术)由于在用其作诊断的同时需要做治疗,所以又衍生出介入放射学这一分支,有的医院仍然和X线、CT、MRI设置在同一个科室,有的医院单独成立介入治疗科。
正电子发射断层扫描仪(PET),由于是需要注射微量的放射性核素才能显像,所以有的医院将其归在核医学科,有的医院将其归入大影像科。
1896年,德国科学家伦琴发现了X光(X射线),从此开启了医学影像诊断的临床学科,定义为放射诊断学。由于只有单一的X线成像设备,方法单一,主要以拍片和透视来诊断疾病,其作用受到了明显的限制,主要用于肺部疾病、骨关节疾病的检查,用途最广,直径依然是比较重要的方法;其次是循环系统、消化系统、泌尿系统等系统疾病的诊断,这方面的作用基本被先进的CT、MRI、超声等取代。作为医学影像学的先河,其作用功不可没,堪称奠基石。

正常胸部X光片
1971年,CT问世;1980年,全身磁共振成像MRI问世。从此,确立了影像诊断的重要地位,同时取代了许多传统影像技术,开启了新时代的影像诊断学科领域,在医学发展史上,是一个划时代的壮举。40多年来发展迅猛,设备更新迅速,新的技术层出不穷,令人目不暇接。业内有这样的说法,半年不学习新知识就会落后。
简单说一说什么是CT。它是英文Computed Tomography的缩写。其实质,是体外发射X射线,穿透人体组织后,用探测器接收剩余的X线,经过电脑计算,将机体组织器官按照数模转换的方法重建还原成为图像,其精度相当高,误差极微。电脑重建的图像是一层一层的,就像切面包片一样,图像的厚度可以根据病灶需要调整,现代CT最薄重建厚度可达0.5mm,很薄了;反之,图像重建厚度太厚容易掩盖小病灶,一般5-10mm为宜。关于CT检查适宜哪些器官、哪些病灶,我们在今后的文章里论述。
正常胸部CT图像

冠状位重建CT胸部图像
再简单说说MRI,磁共振成像。MRI要比CT复杂得多。在磁共振成像发明的初期,科学家们将它命名为核磁共振成像(NMRI),由于有一个“核”字,极容易导致人们将其与核反应、放射性核素联系到一块儿。其实是完全不同的概念,两者风马牛不相及。工作中,很多的朋友、患者问到这个问题,解释了无数遍。其实,简单的想一想,如果真有核辐射损害,怎么可以用于大众检查身体呢?这种误解,在国内外均发生过。后来,国际上统一命名,英文是Magnetic Resonance Imaging,简称MRI。这就是其名称的来源。国内呢,也把“核磁共振”改成了“磁共振”,以免误解。直到今天,依然有老一辈的人叫做“核磁共振”,其实不用担心。那么,磁共振MRI是怎样成像的呢?说起来十分复杂,需要专门学习,是物理学和计算机的科学。简单地说,将人体置于一个静磁场中,我们身体细胞的原子核就会按照静磁场的方向有顺序的排队;此时,在检查部位(比如脑部)发射电磁脉冲(波长数米),这些排好队的原子就会发生偏转,将电磁脉冲停止以后,脑部原子核就会发生共振现象,即昌盛共振信号。此时用信号接收器接受信号,并经过放大、数模转换(与CT雷同),就会得到MRI图像了。从其原理可以看出,除了磁场与脉冲以外,无任何外加因素,对人体不产生危害,孕妇、婴幼儿都可以行MRI检查的,十分安全。自上世纪80年代起,MRI已经广泛运用了40年,时间验证是最可靠的。至于静磁场的场强、电磁脉冲对人体是否有影响,作者将在以后章节阐述。


正常脑MRI图像
还有一个影像诊断学的技术,超声,大家最熟悉的要数B超了。超声,即声波,靠声波的穿透性来检查疾病。这种声音我们听不到,所以叫做超声。超声广泛运用于人体表面器官组织、妇产科、泌尿消化系统、乳腺疾病等等领域,运用上十分方便,安全快捷,可无限制反复使用复查,对人体无害,造福人类。
(作者原创,盗用必究)